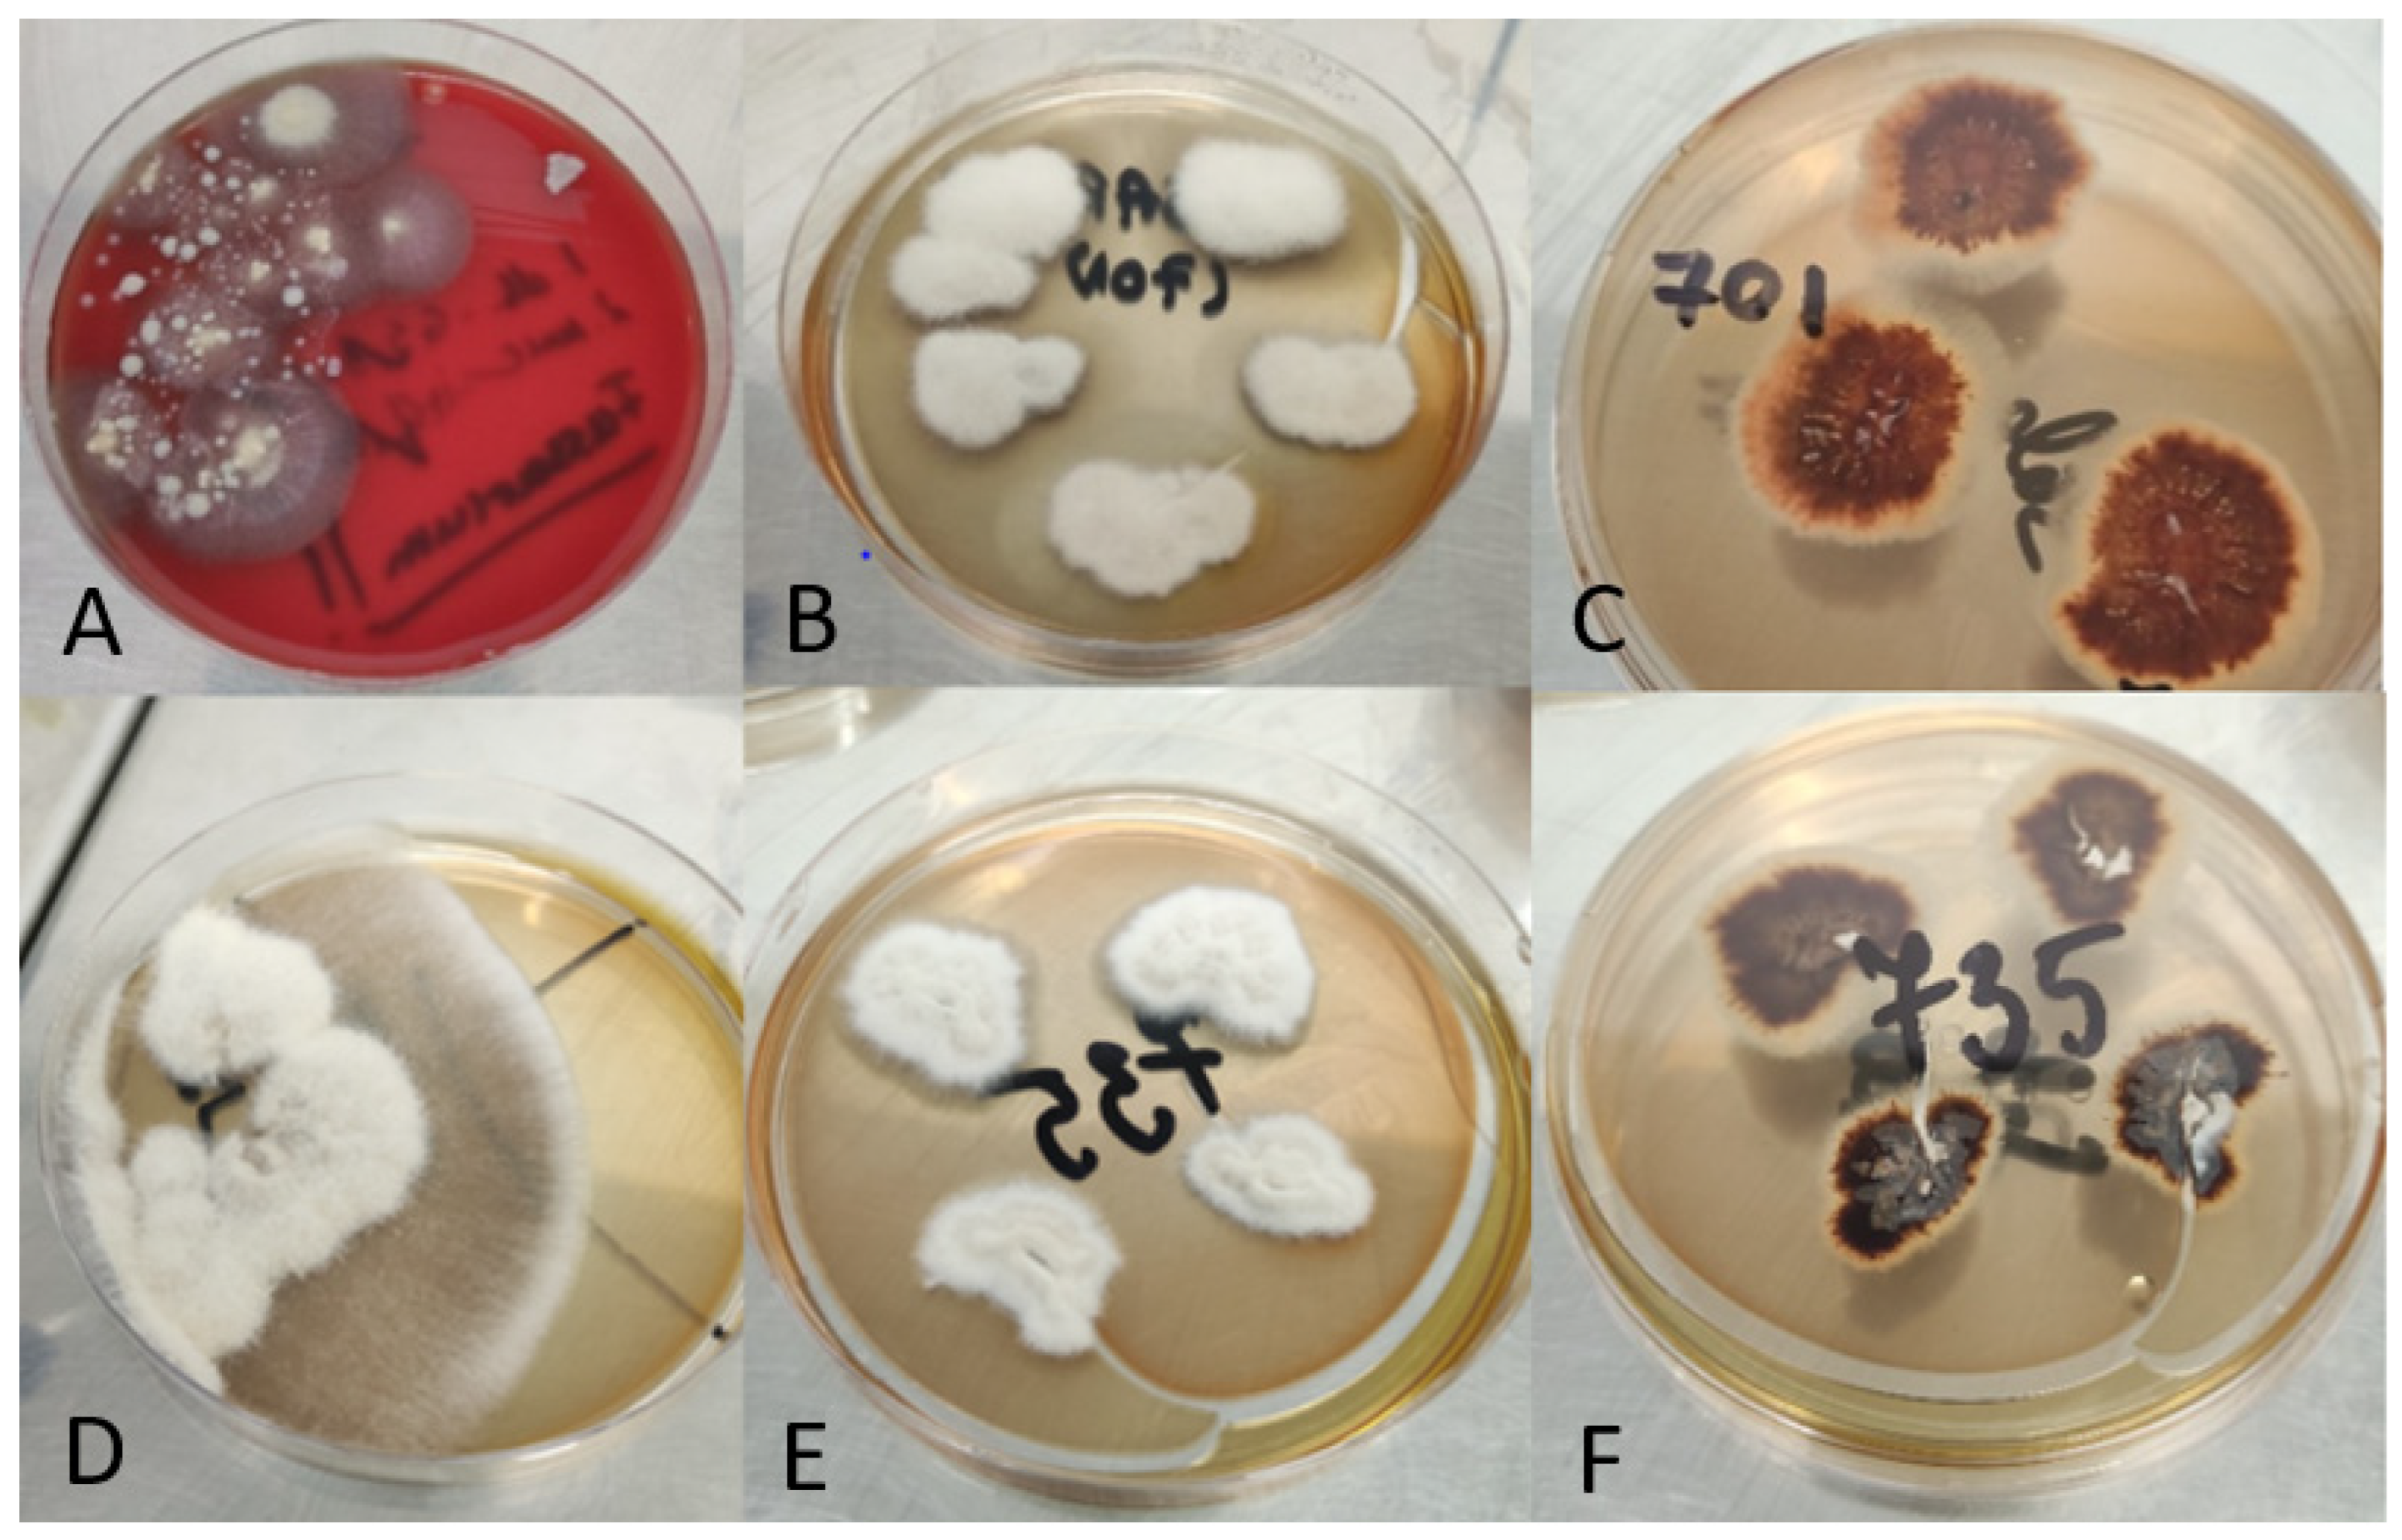

Fusarium spp. in Human Disease: Exploring the Boundaries between Commensalism and Pathogenesis
Abstract
1. Introduction
2. Materials and Methods
2.1. Clinical Isolates of Fusarium spp. and Methods of Identification to the Level of Genus
2.2. Species Identification Using MALDI-TOF MS
2.3. Molecular Testing of Fusarium spp.
2.3.1. Fungal DNA Extraction
2.3.2. Polymerase Chain Reaction
3. Results
4. Discussion
5. Conclusions
Author Contributions
Funding
Institutional Review Board Statement
Informed Consent Statement
Data Availability Statement
Conflicts of Interest
References
- Weber, R.W.; Levetin, E. Allergen of the Month—Fusarium. Ann. Allergy Asthma Immunol. 2014, 112, A11. [Google Scholar] [CrossRef]
- Batista, B.G.; de Chaves, M.A.; Reginatto, P.; Saraiva, O.J.; Fuentefria, A.M. Human Fusariosis: An Emerging Infection That Is Difficult to Treat. Rev. Soc. Bras. Med. Trop. 2020, 53, e20200013. [Google Scholar] [CrossRef]
- Munkvold, G.P. Fusarium Species and Their Associated Mycotoxins. In Mycotoxigenic Fungi; Moretti, A., Susca, A., Eds.; Methods in Molecular Biology; Springer: New York, NY, USA, 2017; Volume 1542, pp. 51–106. ISBN 978-1-4939-6705-6. [Google Scholar]
- Dignani, M.C.; Anaissie, E. Human Fusariosis. Clin. Microbiol. Infect. 2004, 10, 67–75. [Google Scholar] [CrossRef]
- Authority, E.F.S. Deoxynivalenol in Food and Feed: Occurrence and Exposure. EFSA J. 2013, 11, 3379. [Google Scholar] [CrossRef]
- Nucci, F.; Nouér, S.; Capone, D.; Anaissie, E.; Nucci, M. Fusariosis. Semin. Respir. Crit. Care Med. 2015, 36, 706–714. [Google Scholar] [CrossRef]
- García-Tapia, A.; Aznar, E.; García-Martos, P.; Marín, P.; Márquez, A.; Lozano, C.; Mira, J. Fusarium Peritonitis in a Patient on Peritoneal Dialysis. Rev. Iberoam. Micol. 1999, 16, 166–167. [Google Scholar]
- Gaur, S.; Rajgopal, A.; Ashbee, R. A Successfully Treated Case of Peritonitis Due to Fusarium Dimerum. J. Infect. 2010, 61, 86–88. [Google Scholar] [CrossRef]
- Murray, C.K.; Beckius, M.L.; McAllister, K. Fusarium Proliferatum Superficial Suppurative Thrombophlebitis. Mil. Med. 2003, 168, 426–427. [Google Scholar] [CrossRef]
- Gradon, J.D.; Lerman, A.; Lutwick, L.I. Septic Arthritis Due to Fusarium Moniliforme. Clin. Infect. Dis. 1990, 12, 716–717. [Google Scholar] [CrossRef]
- Jakle, C.; Leek, J.C.; Olson, D.A.; Robbins, D.L. Septic Arthritis Due to Fusarium Solani. J. Rheumatol. 1983, 10, 151–153. [Google Scholar]
- Sierra-Hoffman, M.; Paltiyevich-Gibson, S.; Carpenter, J.L.; Hurley, D.L. Fusarium Osteomyelitis: Case Report and Review of the Literature. Scand. J. Infect. Dis. 2005, 37, 237–240. [Google Scholar] [CrossRef]
- Ahearn, D.G.; Zhang, S.; Doyle Stulting, R.; Schwam, B.L.; Simmons, R.B.; Ward, M.A.; Pierce, G.E.; Crow, S.A. Fusarium Keratitis and Contact Lens Wear: Facts and Speculations. Med. Mycol. 2008, 46, 397–410. [Google Scholar] [CrossRef]
- Proença-Pina, J.; Ssi Yan Kai, I.; Bourcier, T.; Fabre, M.; Offret, H.; Labetoulle, M. Fusarium Keratitis and Endophthalmitis Associated with Lens Contact Wear. Int. Ophthalmol. 2010, 30, 103–107. [Google Scholar] [CrossRef]
- Dananché, C.; Cassier, P.; Sautour, M.; Gautheron, N.; Wegrzyn, J.; Perraud, M.; Bienvenu, A.-L.; Nicolle, M.-C.; Boibieux, A.; Vanhems, P. Fungaemia Caused by Fusarium Proliferatum in a Patient without Definite Immunodeficiency. Mycopathologia 2015, 179, 135–140. [Google Scholar] [CrossRef]
- Macêdo, D.P.C.; Neves, R.P.; Fontan, J.; Souza-Motta, C.M.; Lima, D. A Case of Invasive Rhinosinusitis by Fusarium Verticillioides (Saccardo) Nirenberg in an Apparently Immunocompetent Patient. Med. Mycol. 2008, 46, 499–503. [Google Scholar] [CrossRef]
- Poignon, C.; Blaize, M.; Vezinet, C.; Lampros, A.; Monsel, A.; Fekkar, A. Invasive Pulmonary Fusariosis in an Immunocompetent Critically Ill Patient with Severe COVID-19. Clin. Microbiol. Infect. 2020, 26, 1582–1584. [Google Scholar] [CrossRef]
- Nucci, M.; Anaissie, E. Fusarium Infections in Immunocompromised Patients. Clin. Microbiol. Rev. 2007, 20, 695–704. [Google Scholar] [CrossRef]
- Dutta, P.; Premkumar, A.; Chakrabarti, A.; Shah, V.N.; Behera, A.; De, D.; Rudramurthy, S.M.; Bhansali, A. Fusarium Falciforme Infection of Foot in a Patient with Type 2 Diabetes Mellitus: A Case Report and Review of the Literature. Mycopathologia 2013, 176, 225–232. [Google Scholar] [CrossRef]
- O’Donnell, K.; Sutton, D.A.; Fothergill, A.; McCarthy, D.; Rinaldi, M.G.; Brandt, M.E.; Zhang, N.; Geiser, D.M. Molecular Phylogenetic Diversity, Multilocus Haplotype Nomenclature, and In Vitro Antifungal Resistance within the Fusarium Solani Species Complex. J. Clin. Microbiol. 2008, 46, 2477–2490. [Google Scholar] [CrossRef]
- Park, S.-H.; Kim, D.; Kim, J.; Moon, Y. Effects of Mycotoxins on Mucosal Microbial Infection and Related Pathogenesis. Toxins 2015, 7, 4484–4502. [Google Scholar] [CrossRef]
- Guarro, J.; Gené, J. Opportunistic Fusarial Infections in Humans. Eur. J. Clin. Microbiol. Infect. Dis. Off. Publ. Eur. Soc. Clin. Microbiol. 1995, 14, 741–754. [Google Scholar] [CrossRef]
- Sugawara, Y.; Nakase, K.; Nakamura, A.; Ohishi, K.; Sugimoto, Y.; Fujieda, A.; Monma, F.; Suzuki, K.; Masuya, M.; Matsushima, Y.; et al. Clinical Utility of a Panfungal Polymerase Chain Reaction Assay for Invasive Fungal Diseases in Patients with Haematologic Disorders. Eur. J. Haematol. 2013, 90, 331–339. [Google Scholar] [CrossRef]
- Dong, H.; Kemptner, J.; Marchetti-Deschmann, M.; Kubicek, C.P.; Allmaier, G. Development of a MALDI Two-Layer Volume Sample Preparation Technique for Analysis of Colored Conidia Spores of Fusarium by MALDI Linear TOF Mass Spectrometry. Anal. Bioanal. Chem. 2009, 395, 1373–1383. [Google Scholar] [CrossRef]
- Verwer, P.E.B.; van Leeuwen, W.B.; Girard, V.; Monnin, V.; van Belkum, A.; Staab, J.F.; Verbrugh, H.A.; Bakker-Woudenberg, I.A.J.M.; van de Sande, W.W.J. Discrimination of Aspergillus Lentulus from Aspergillus Fumigatus by Raman Spectroscopy and MALDI-TOF MS. Eur. J. Clin. Microbiol. Infect. Dis. 2014, 33, 245–251. [Google Scholar] [CrossRef]
- Alshawa, K.; Beretti, J.-L.; Lacroix, C.; Feuilhade, M.; Dauphin, B.; Quesne, G.; Hassouni, N.; Nassif, X.; Bougnoux, M.-E. Successful Identification of Clinical Dermatophyte and Neoscytalidium Species by Matrix-Assisted Laser Desorption Ionization-Time of Flight Mass Spectrometry. J. Clin. Microbiol. 2012, 50, 2277–2281. [Google Scholar] [CrossRef]
- Normand, A.-C.; Cassagne, C.; Gautier, M.; Becker, P.; Ranque, S.; Hendrickx, M.; Piarroux, R. Decision Criteria for MALDI-TOF MS-Based Identification of Filamentous Fungi Using Commercial and in-House Reference Databases. BMC Microbiol. 2017, 17, 25. [Google Scholar] [CrossRef]
- Marinach-Patrice, C.; Lethuillier, A.; Marly, A.; Brossas, J.-Y.; Gené, J.; Symoens, F.; Datry, A.; Guarro, J.; Mazier, D.; Hennequin, C. Use of Mass Spectrometry to Identify Clinical Fusarium Isolates. Clin. Microbiol. Infect. 2009, 15, 634–642. [Google Scholar] [CrossRef]
- De Carolis, E.; Posteraro, B.; Lass-Flörl, C.; Vella, A.; Florio, A.R.; Torelli, R.; Girmenia, C.; Colozza, C.; Tortorano, A.M.; Sanguinetti, M.; et al. Species Identification of Aspergillus, Fusarium and Mucorales with Direct Surface Analysis by Matrix-Assisted Laser Desorption Ionization Time-of-Flight Mass Spectrometry. Clin. Microbiol. Infect. 2012, 18, 475–484. [Google Scholar] [CrossRef]
- Lau, A.F.; Drake, S.K.; Calhoun, L.B.; Henderson, C.M.; Zelazny, A.M. Development of a Clinically Comprehensive Database and a Simple Procedure for Identification of Molds from Solid Media by Matrix-Assisted Laser Desorption Ionization–Time of Flight Mass Spectrometry. J. Clin. Microbiol. 2013, 51, 828–834. [Google Scholar] [CrossRef]
- Normand, A.-C.; Cassagne, C.; Ranque, S.; L’Ollivier, C.; Fourquet, P.; Roesems, S.; Hendrickx, M.; Piarroux, R. Assessment of Various Parameters to Improve MALDI-TOF MS Reference Spectra Libraries Constructed for the Routine Identification of Filamentous Fungi. BMC Microbiol. 2013, 13, 76. [Google Scholar] [CrossRef]
- Godoy, P.; Cano, J.; Gené, J.; Guarro, J.; Höfling-Lima, A.L.; Lopes Colombo, A. Genotyping of 44 Isolates of Fusarium Solani, the Main Agent of Fungal Keratitis in Brazil. J. Clin. Microbiol. 2004, 42, 4494–4497. [Google Scholar] [CrossRef]
- Cuénod, A.; Foucault, F.; Pflüger, V.; Egli, A. Factors Associated With MALDI-TOF Mass Spectral Quality of Species Identification in Clinical Routine Diagnostics. Front. Cell. Infect. Microbiol. 2021, 11, 646648. [Google Scholar] [CrossRef]
- Mahmoudi, S.; Masoomi, A.; Ahmadikia, K.; Tabatabaei, S.A.; Soleimani, M.; Rezaie, S.; Ghahvechian, H.; Banafsheafshan, A. Fungal Keratitis: An Overview of Clinical and Laboratory Aspects. Mycoses 2018, 61, 916–930. [Google Scholar] [CrossRef]
- Nucci, M.; Varon, A.G.; Garnica, M.; Akiti, T.; Barreiros, G.; Trope, B.M.; Nouér, S.A. Increased Incidence of Invasive Fusariosis with Cutaneous Portal of Entry, Brazil. Emerg. Infect. Dis. 2013, 19, 1567–1572. [Google Scholar] [CrossRef]
- Cighir, A.; Mare, A.D.; Cighir, T.; Coșeriu, R.L.; Vintilă, C.; Man, A. Filamentous Fungi Infections: Yet Another Victim of COVID-19? Life 2023, 13, 546. [Google Scholar] [CrossRef]
- Thomas, B.; Audonneau, N.C.; Machouart, M.; Debourgogne, A. Fusarium Infections: Epidemiological Aspects over 10 Years in a University Hospital in France. J. Infect. Public Health 2020, 13, 1089–1093. [Google Scholar] [CrossRef]
- Egbuta, M.A.; Mwanza, M.; Babalola, O.O. Health Risks Associated with Exposure to Filamentous Fungi. Int. J. Environ. Res. Public. Health 2017, 14, 719. [Google Scholar] [CrossRef]
- Hay, R.J. Fusarium Infections of the Skin. Curr. Opin. Infect. Dis. 2007, 20, 115–117. [Google Scholar] [CrossRef]
- van Diepeningen, A.D.; Brankovics, B.; Iltes, J.; van der Lee, T.A.J.; Waalwijk, C. Diagnosis of Fusarium Infections: Approaches to Identification by the Clinical Mycology Laboratory. Curr. Fungal Infect. Rep. 2015, 9, 135–143. [Google Scholar] [CrossRef]
- Nucci, M.; Barreiros, G.; Akiti, T.; Anaissie, E.; Nouér, S.A. Invasive Fusariosis in Patients with Hematologic Diseases. J. Fungi 2021, 7, 815. [Google Scholar] [CrossRef]
- Cornea, C.P.; Israel-Roming, F.; Ciuca, M.; Voaides, C. Natural Occurrence of Fusarium Species and Corresponding Chemotypes in Wheat Scab Complex from Romania. Rom. Biotechnol. Lett. 2013, 18, 8787–8795. [Google Scholar]
- Yüksektepe, B.; Sefer, Ö.; Varol, G.; Teker, T.; Arslan, M.; Çetin, B.; Mert, F.; Yörük, E.; Albayrak, G. Identification of Fusarium Graminearum and Fusarium Culmorum Isolates via Conventional and Molecular Methods. Eur. J. Biol. 2022, 81, 107–116. [Google Scholar] [CrossRef]
- Haratian, M.; Sharifnabi, B.; Alizadeh, A.; Safaie, N. PCR Analysis of the Tri13 Gene to Determine the Genetic Potential of Fusarium Graminearum Isolates from Iran to Produce Nivalenol and Deoxynivalenol. Mycopathologia 2008, 166, 109–116. [Google Scholar] [CrossRef]
- Arif, M.; Pani, D.R.; Zaidi, N.W.; Singh, U.S. PCR-Based Identification and Characterization of Fusarium Sp. Associated with Mango Malformation. Biotechnol. Res. Int. 2011, 2011, e141649. [Google Scholar] [CrossRef]
- Sobrova, P.; Adam, V.; Vasatkova, A.; Beklova, M.; Zeman, L.; Kizek, R. Deoxynivalenol and Its Toxicity. Interdiscip. Toxicol. 2010, 3, 94–99. [Google Scholar] [CrossRef]
- Wu, T.G.; Keasler, V.V.; Mitchell, B.M.; Wilhelmus, K.R. Immunosuppression Affects the Severity of Experimental Fusarium Solani Keratitis. J. Infect. Dis. 2004, 190, 192–198. [Google Scholar] [CrossRef]
- Anutarapongpan, O.; Maestre-Mesa, J.; Alfonso, E.C.; O’Brien, T.P.; Miller, D. Multiplex Polymerase Chain Reaction Assay for Screening of Mycotoxin Genes From Ocular Isolates of Fusarium Species. Cornea 2018, 37, 1042–1046. [Google Scholar] [CrossRef]
- Schrecker, J.; Seitz, B.; Berger, T.; Daas, L.; Behrens-Baumann, W.; Auw-Hädrich, C.; Schütt, S.; Kerl, S.; Rentner-Andres, S.; Hof, H. Malignant Keratitis Caused by a Highly-Resistant Strain of Fusarium Tonkinense from the Fusarium Solani Complex. J. Fungi 2021, 7, 1093. [Google Scholar] [CrossRef]

Disclaimer/Publisher’s Note: The statements, opinions and data contained in all publications are solely those of the individual author(s) and contributor(s) and not of MDPI and/or the editor(s). MDPI and/or the editor(s) disclaim responsibility for any injury to people or property resulting from any ideas, methods, instructions or products referred to in the content. |
© 2023 by the authors. Licensee MDPI, Basel, Switzerland. This article is an open access article distributed under the terms and conditions of the Creative Commons Attribution (CC BY) license (https://creativecommons.org/licenses/by/4.0/).
Share and Cite
Cighir, A.; Mare, A.D.; Vultur, F.; Cighir, T.; Pop, S.D.; Horvath, K.; Man, A. Fusarium spp. in Human Disease: Exploring the Boundaries between Commensalism and Pathogenesis. Life 2023, 13, 1440. https://doi.org/10.3390/life13071440
Cighir A, Mare AD, Vultur F, Cighir T, Pop SD, Horvath K, Man A. Fusarium spp. in Human Disease: Exploring the Boundaries between Commensalism and Pathogenesis. Life. 2023; 13(7):1440. https://doi.org/10.3390/life13071440
Chicago/Turabian StyleCighir, Anca, Anca Delia Mare, Florina Vultur, Teodora Cighir, Suzana Doina Pop, Karin Horvath, and Adrian Man. 2023. "Fusarium spp. in Human Disease: Exploring the Boundaries between Commensalism and Pathogenesis" Life 13, no. 7: 1440. https://doi.org/10.3390/life13071440
APA StyleCighir, A., Mare, A. D., Vultur, F., Cighir, T., Pop, S. D., Horvath, K., & Man, A. (2023). Fusarium spp. in Human Disease: Exploring the Boundaries between Commensalism and Pathogenesis. Life, 13(7), 1440. https://doi.org/10.3390/life13071440

